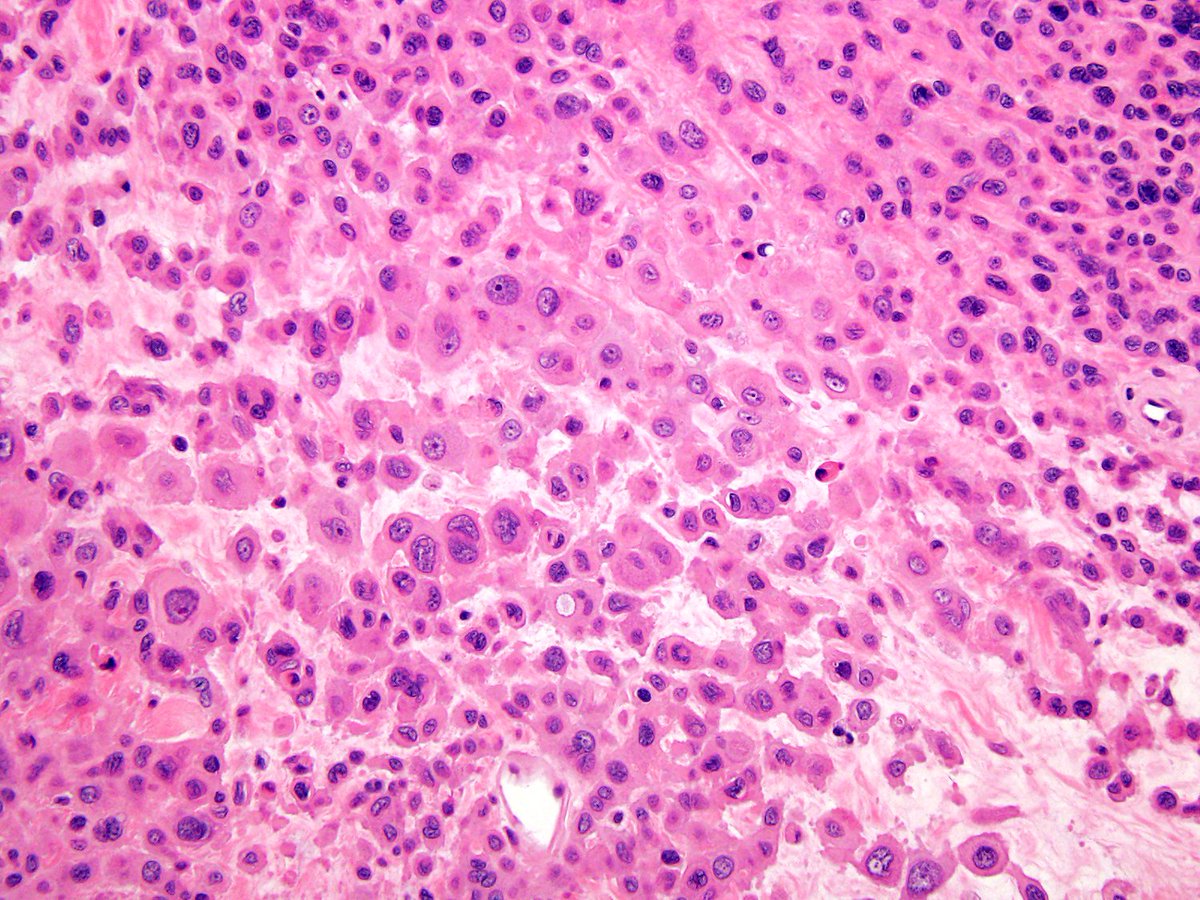
ST mass, inguinal. KRT+/loss of INI.  Nice example of proximal-type

Jeffrey Cloutier, MD, PhD
@jcloutiermd
Dermatopathologist, Bone / Soft Tissue Pathologist.
Assistant Professor of Pathology at Dartmouth Geisel School of Medicine.
ID: 988292397971816448
https://geiselmed.dartmouth.edu/faculty/facultydb/view.php/?uid=8154 23-04-2018 05:44:04
517 Tweet
2,2K Followers
1,1K Following







We’ve long known that epithelioid #sarcoma can be divided into proximal and classic subtypes, which have distinct clinical and morphologic features. Now, a new study by Sigalotti et al. gives us molecular insight behind these subtypes. Fascinating work! sciencedirect.com/science/articl…

Big congrats to our PGY-3 Dr. Paige O'Connor for the latest publication with our amazing faculty Darcy A. Kerr #DHPathRes Check it out: pubmed.ncbi.nlm.nih.gov/39533889/






Dartmouth Health Patholology is growing and seeking academic pathologists to join our team. Top priorities: GYN, Breast, GU, Cyto, & GI subspecialty training. Salaries and facility resources are highly desirable. Northern New England is a lifestyle hidden gem. DM for add'l info.




If you couldn’t attend Dr. Kerr’s Darcy A. Kerr lecture on fibro-osseous lesions of the craniofacial skeleton, check it out later with the on-demand option on the #USCAP25 website. Highly recommended! Dartmouth Health Pathology Residency


My colleagues! Sign up! 👇 Jeremiah Karrs, DO Dartmouth Health Pathology Residency